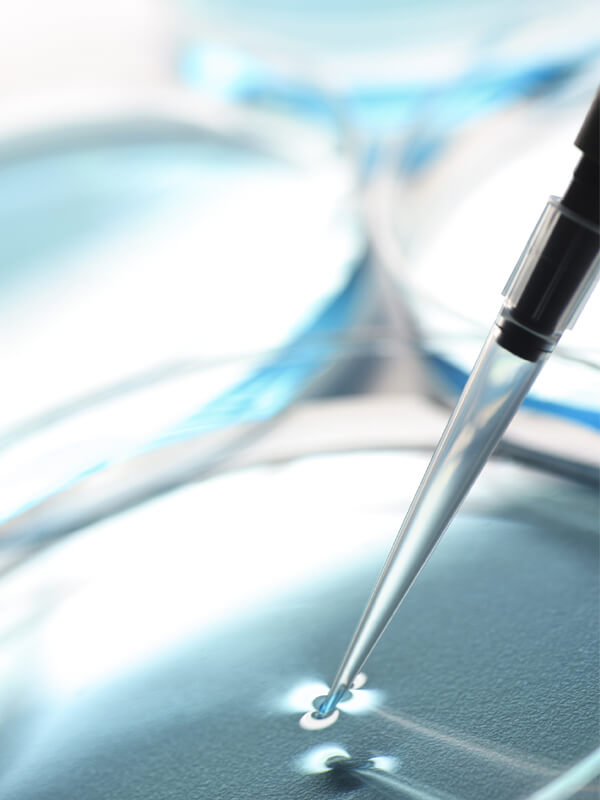

JCE BIOTECHNOLOGY
Forte de 30 années d’expérience dans la conception, la fabrication et la maintenance d’isolateurs sur-mesure et de solutions personnalisées en isotechnie pour l’Industrie pharmaceutique, les Hôpitaux et Laboratoires, JCE BIOTECHNOLOGY propose un large panel d’équipements et de produits répondant aux normes BPF, cGMP et ISO en constante évolution, aux besoins spécifiques des salles blanches et autres environnements maîtrisés :
– Isolateurs
– Systèmes de bio-décontamination APA et H2O2
– Sas de Transfert
– Systèmes de Transfert Sécurisé de type RTP
– Panel d’accessoires et de consommables à usage unique.
JCE BIOTECHNOLOGY intègre également les prestations de qualification, validation, maintenance et formation.
SÉCURITÉ ET PRÉVENTION DE LA CONTAMINATION
La maîtrise de la contamination est devenue un enjeu commun à un nombre croissant de secteurs d’activité ayant désormais recours aux salles blanches et environnements stériles.
Les solutions proposées par JCE BIOTECHNOLOGY s’adressent à tous les secteurs d’activité dans le domaine des environnements et procédés propres, ultra-propres ou stériles.